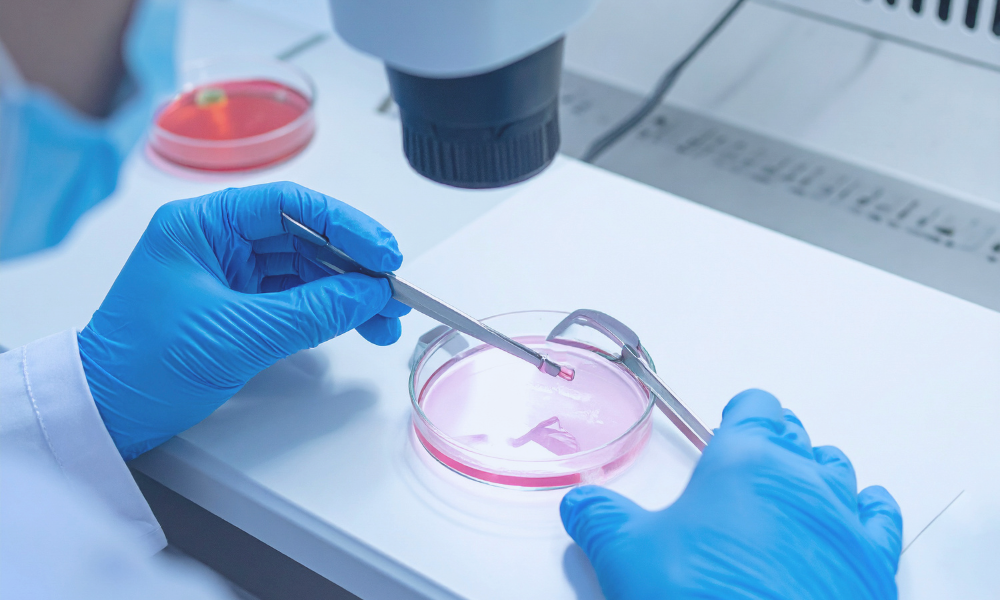
Smart Dust in Healthcare {{brizy_dc_image_alt entityId=

智能尘埃实际上是一种微型机电无线设备,例如微型机器人、传感器或其他类似设备,能够检测温度、振动、化学物质、光线等等。智能尘埃在各个领域都有诸多优势。
没有人能想到,如此微小的空间竟然蕴藏着如此强大的功能。
这些微机电系统(MEMS)拥有独立的电源,具备通信能力,甚至可以安装摄像头等等。
由于体积微小,智能尘埃可以悬浮在任何环境中,用于监测或收集数据,而不会改变或干扰实际过程。
它们可以无线传输数据到报告基站。这得益于微尺度3D打印技术。此外,这些微型机器人使用的镜头可以捕捉到极其清晰的图像。
现在你可能已经在猜测智能尘埃的用途了。
想想传统的卧底行动是怎么进行的?潜入目标人物的房间,把摄像头藏在衬衫口袋里,或者放在包里?想想智能尘埃会如何改变这些行动。
只需把这种尘埃撒进房间,这并不难,因为除非有人一直用显微镜、眼镜或放大镜观察,否则根本没人能看到它。
谁知道这会不会成为未来的另一项发明呢?等等,我是不是刚刚给了他们一个灵感?不过,反正也没什么风险,对吧?
智能尘埃的应用
- 用于安全目的的无线监控。
- 用于维护目的。
- 识别系统故障等薄弱环节。
- 从诊断和手术到监测设备,智能尘埃的应用在医疗保健行业前景广阔。
- 用于GPS系统,借助智能尘埃节点追踪移动轨迹。
智能微尘的优势
医疗保健
正如我之前所说,智能尘埃在医疗保健行业有着巨大的应用前景。它可以深入人体内部,帮助诊断疾病,这是以前无法实现的。
此外,它甚至可以在人体表面发挥作用。例如,可以通过微型传感器识别压力点,这些传感器可以分布在需要安装假肢的区域。
另一方面,它还可以辅助手术。这些微小颗粒可以植入体内,收集信息,从而帮助医生确定手术的最佳时机和方式。
农业
首先,智能尘埃可以用来判断土壤是否适宜植物生长。此外,它还可以用于收集诸如作物收获时间等数据。
另外,在温室等可控环境中,智能尘埃可以用来控制温度和湿度,还可以判断土壤是否需要施肥或含水量。
智能尘埃的另一个好处是,如果这项技术得到充分发展,它或许可以完全取代人工种植植物、水果和蔬菜的方式,从而提高我们食物的质量和纯度。是不是很神奇?
军事
它可以帮助监测危险或难以进入区域的活动。
智能尘埃的其他优势包括追踪敌人或检测空气中的放射性物质或有毒物质。
智能尘埃还可用于安全和监控目的。
科学研究
利用智能尘埃可以启动众多科学项目,例如将智能尘埃送入太空或人类未知的行星,以收集宇宙数据。
此外,它还可以用于在发生地震、龙卷风、飓风和火山爆发等自然灾害时提供早期预警。
交通运输
智能尘埃可用于监测运输货物的状况。对于易腐物品,智能尘埃还可以用于维持预设的受控环境,以保持货物新鲜。
此外,如果设备或预设条件出现任何故障,它还可以发送求救信号。
智能尘埃还有许多其他优势。未来,谁知道智能尘埃还能做什么呢?或许它可以被改进以增强其功能。
但我们知道的是,它是一种大规模的物联网应用。正如人们常说的,小事物也能成就大事。从长远来看,智能尘埃究竟是会带来灾难还是益处?我们拭目以待。